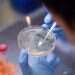
צילום: AFP המרוץ לחיסון: בקהילה המדעית מסתמנת אופטימיות

המחאות ברחוב בלפור ובכיכר רבין מסמנות בבירור את השלב השלישי של התפתחות השמאל הישראלי, הוא הוא הופך לתנועת קצה פוליטית, מחוץ לגבולות הקונצנזוס הישראלי ורחוק מאד מגלגוליו הקודמים.
כתבות נוספות באתר מקור ראשון:
– הטרור ביו"ש: 145 פצועים בפיגועי אבנים ובקבוקי תבערה בימי הקורונה
– השתוללות בכיף: השמאל לא למד לקח ממלחמות אחים
– אפשר להירגע: העולם לא הולך לקרוס בגלל קורונה
הראשון הוא הגלגול הלאומי, בשלב הנחת היסודות להקמת המדינה. המתח שאפיין את תנועת העבודה בשנות העשרים המוקדמות, בין תפיסת העולם החברתית-מעמדית לבין תפיסת העולם הציונית, הוכרע בצורה ברורה על ידי דוד בן גוריון לטובת הקוטב הלאומי-ממלכתי. מנהיגות מפא"י אימצה תפיסת עולם לאומית ברורה אשר הדריכה אותה הן ביחס לניהול אתגרי הביטחון מול הסביבה החיצונית והן ביחס לניהול אתגרי הכלכלה והחברה מבית.

הגלגול השני של השמאל נולד בתחילת שנות התשעים, במציאות שבה התאפשר אמנם התאפשר ל"ישראל השנייה" לבטא את קולה בשדה הפוליטי והחברתי לאחר המהפך של 1977 אבל טרם הושלם תהליך העתקת מרכז הכובד לימין. המערכת הפוליטית אופיינה במבנה דו-גושי. בצל תהליך שחיקת ההגמוניה של מפלגת העבודה, החל השמאל הישראלי לנסח מחדש את תפיסת עולמו כשהוא טוען אותה בחזון ליברלי קוסמופוליטי כסוג של אמירה מתחרה והופכית לחזון הקולקטיבי האתנוצנטרי של הימין.
שיאו של התהליך ניכר בתקופת ממשלת רבין השנייה, שהביאה לעולם שני צאצאים בדמות אותו חזון: האחד, מושג השלום ותפיסת הסדרי הקבע עם השכנים הפלסטינים והערבים; והשני, רעיון המהפכה החוקתית שגילמה את הכמיהה לחברה המתעדפת את שיח הזכויות הפרסונלי על פני הגדרות זהות לאום. הדחייה של החברה הישראלית מזה ושל המזרח התיכון מזה את חזונו העדכני של השמאל התבטאה פוליטית בשקיעתה של מפלגת העבודה, כשהיא מקבעת לראשונה באופן מוחלט את הגמוניית הימין.
הכישלון הצורב בהעמדת חלופה רעיונית רלוונטית והפער שהלך והעמיק בין מאווייו של השמאל הישראלי לבין אחיזתו המוגבלת בשדה החברתי ונוכחותו המצומקת בשדה הפוליטי, היו המצע שעליו צמח הגלגול השלישי הנוכחי. תהליך זה הואץ עוד יותר ככל שגברה הפופולריות של בנימין נתניהו, ובשנה האחרונה גם נוכח הקושי לייצר היפוך פוליטי באמצעות הביטחוניסטים של כחול לבן. הגלגול השלישי מאופיין באימוץ תפיסת עולם בעלת יסודות אנטי-מדינתיים, המבקשת לקעקע את יסודותיה של הדמוקרטיה במובנה הפורמלי המוגדרת דרך מחויבות לעיקרון הכרעת העם ושמירת שלטון החוק.
בשם אותו ניתוק הופך הרעיון האנרכיסטי למרכז הכובד הרעיוני של חלקים מהשמאל. השחיקה המוחלטת במעמדן של מפלגות השמאל הציוניות ובראש ובראשונה מפלגת העבודה, מאיצה את העתקת מרכז הכובד הפוליטי של השמאל מהשדה הפרלמנטרי אל השדה הלא פורמלי: הרחובות, הכיכרות והצמתים. כך הפכו ההפגנות האחרונות למפגני התנגדות לסדר המדינתי תוך סיגול דפוסי מחאה דומים לאלה שנצפו לאחרונה בארצות הברית. הסדר הציבורי והחוק היו למרמס בידי אלה המתקשים לייצר מיזם רעיוני קונסטרוקטיבי למחאה ולרוב מסתפקים באימוץ שיח פוליטי נגטיבי המהווה חיבור אקלקטי בין סיסמאות שונות (מאבק בשחיתות, מאבק בניהול משבר הקורונה, מאבק על עתיד הצעירים וכיוצא בזה).
אולם, חמורה מכך היא הגלישה המסתמנת למעשים של אלימות פוליטית שבין ביטויה פגיעה ברכוש, ונדליזם וכמובן עימותים קשים עם כוחות האכיפה המלווים בתהליך של דה-לגיטימציה לעשייתם הציבורית. את אלה צריך לנתח ולהבין כתוצר הלוואי של אימוץ תפיסת קצה רעיונית ההולכת ומאבדת אחיזה עם כל מה שמגדיר את מהותה של ישראל לא רק כמדינה יהודית-ציונית, ברוח הגלגול השני של חלקים מהשמאל, אלא כמסגרת פוליטית-מדינתית שנועדה לאפשר את התנאים הבסיסיים לקיומם של חיים תקינים לכלל תושביה.
הגלגול השלישי של השמאל הישראלי מסב אותו ומקבע את מעמדו כתנועת קצה אידיאולוגית ובכך יוצר מדרון חלקלק הטומן בחובו פוטנציאל רע במיוחד. החיבור המסתמן בין עוצמת האנרגיות השליליות המפעפעת ברחוב בחסות משבר הקורונה ובחסות חוסר ההשלמה עם תוצאות מערכות הבחירות האחרונות, לבין חציית הרוביקון בכל הנוגע לאימוץ פרקטיקות של אלימות לצד מיקוד הזעם ברשויות המדינה והאכיפה וספציפית בראש הממשלה, מחייב הרמת דגל אדום, להבדיל מזה השחור, בטרם נתגלגל לתרחישים קשים, לרבות הרצח הפוליטי הבא במדינת ישראל.
דווקא בשעה הקריטית הנוכחית, בה מאותגרת המדינה והחברה הישראלית כאחד בצל משבר הקורונה, נדרשת פעולה חברתית-פוליטית אחראית וזהירה, לא לשם פירוק וקעקוע יסודותיו של הבית בשם תפיסה אוטופית חסרת גבולות וחסרת אחריות, אלא לתכלית הפוכה לחלוטין של חיזוק החוסן הלאומי. במעשה זה שתכליתו לבלום את ההסלמה ואת השתלטות הקצוות האידיאולוגיים על השדה החברתי-פוליטי, מוטלת אחריות גדולה על כתפי המנהיגות הפוליטית הישראלית שבעת הנוכחית מגלים, אלה בשורות הקואליציה בוודאי אלה באופוזיציה, שפה רפה מידי מול המתרחש בשם הכניעה לפופוליזם שהולך ומכרסם ביסודות הסדר הדמוקרטי הישראלי.